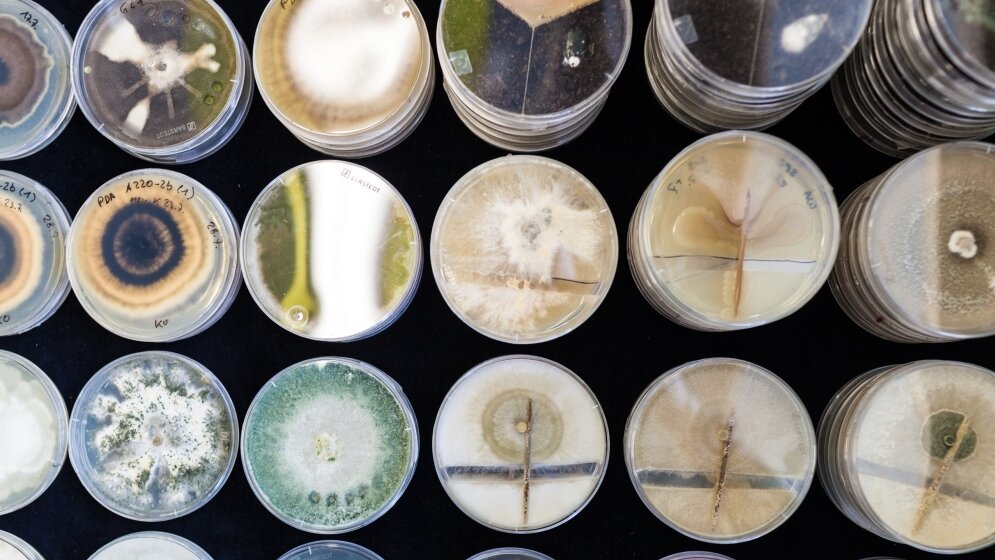
Photodynamischer Effekt

Wenn es bis in den letzten Winkel hygienisch rein sein soll, reichen Staubwedel und Putzlappen nicht aus. Starke chemische Reinigungsmittel sind in der Pharma- und Lebensmittelproduktion und im klinischen Bereich aber fehl am Platz. „Besonders schwierig ist es, Personen zu dekontaminieren. Sie sind in Reinräumen der größte verunreinigende Risikofaktor“, sagt Gabriele Berg vom Institut für Umweltbiotechnologie der TU Graz. Eine „erhellende“ Alternative findet sich in der photodynamischen Desinfektion von Kleidung, eine Technologie, die ihren Ursprung in einem gemeinsamen Projekt der TU Graz und des Research Center Pharmaceutical Engineering (RCPE) hat.
Desinfektion mittels Licht
Die zugrunde liegende Technologie der Erfindung nennt sich „Photodynamic Disinfection certified Technology“, kurz PDcT. Gabriele Berg erklärt: „Wir nutzen den photodynamischen Effekt, der es einem Farbstoff ermöglicht, auf spezielle Wellenlängen des Lichts zu reagieren. In dieser Reaktion bildet sich hochreaktiver Sauerstoff, der wiederum mit unerwünschten Keimen reagiert und deren Wachstum verhindert“. Erst seit kurzem ist die photodynamische Desinfektion auch auf speziell gefärbter (Arbeits-)Kleidung möglich. „Für den Menschen ist diese Art der Dekontamination völlig ungefährlich“, so Berg. Mit PDcT ist es erstmals möglich, Personen in ihrem Arbeitsumfeld zu dekontaminieren und die Keimübertragung durch den Menschen zu minimieren.
Die Anwendungsmöglichkeiten der neuen Technologie sind vielfältig: In Reinraum-Bereichen der Pharma- und Lebensmittelproduktion ist sie heute schon erfolgreich im Einsatz. Andere künftige Anwendungsgebiete sind sensible klinische Bereiche wie die Onkologie, Neonatalogie, Intensivstationen oder Nachbetreuungseinrichtungen für Transplant-Patienten. Das Team rund um Gabriele Berg hat diese besondere Antikeim-Technologie mit zwei weiteren Instituten der TU Graz, dem Kompetenzzentrum RCPE und verschiedenen Unternehmenspartnern weiterentwickelt. Das Patent hält die Partnerfirma Ortner Reinraumtechnik. Sie hat dafür kürzlich den Sonderpreis ECONOVIUS im Rahmen des Staatspreises für Innovation 2016 und eine Nominierung zum Houskapreis eingeheimst.
Keimbekämpfung aus der Natur
Neben dem ECONOVIUS, dem Science2Business Award 2011 und dem Kärntner Innovationspreis trägt die gemeinsame Forschung zwischen TU Graz, RCPE und Unternehmenspartnern viele weitere Früchte: etwa das Startup roombiotic, das sich auf Desinfektionsverfahren für schwer zugängliche Bereiche spezialisiert und ebenfalls bereits drei Patente angemeldet hat. Roombiotic setzt flüchtige Wirkstoffe ein, die nützliche Mikroorganismen enthalten. Wie Aromastoffe breiten sie sich über die Luft aus und wehren Keime auf verschiedenen Oberflächen und in Nischenbereichen schonend in der Luft ab. (idw, red)
Hintergrundinformationen:
Weitere Informationen unter www.roombiotic.com
Hier geht es zum Clip über die preisgekrönte Desinfektionstechnologie, den der Unternehmenspartner Ortner Reinraumtechnik auf seiner Website veröffentlicht hat.
An der TU Graz ist dieses Forschungsprojekt im Field of Expertise „Human & Biotechnology“ verankert, einem von fünf strategischen Forschungsschwerpunkten.
Artikel teilen